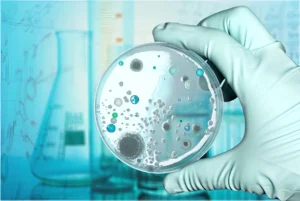
Invasive-Fungal-Diseases-in-Adult-Patients-in-ICU

Diagnostic Approaches to Invasive Candidiasis: Challenges and New Perspectives
Introduction Invasive candidiasis is a serious fungal infection seen in 2–10% of ICU patients, driven by Candida species that can enter the bloodstream, form biofilms,

Introduction Invasive candidiasis is a serious fungal infection seen in 2–10% of ICU patients, driven by Candida species that can enter the bloodstream, form biofilms,

Introduction Pneumonia is common and potentially fatal, with CAP causing high hospitalizations and significant mortality. Its economic burden is substantial, and HAP/VAP further increase mortality,

Introduction The studies presented in this issue collectively underscore the growing potential of novel peptides as foundations for next-generation antibacterial agents—especially in the context of

Introduction Lower respiratory tract infections (LRTIs) cause millions of deaths globally each year and remain a major health and economic burden, especially in low- and

Introduction Leptospiros is thought to be the most widespread zoonosis in the world. A systematic review estimated that there are more than one million cases

Introduction Sepsis remains a major global health challenge due to its complexity and delayed recognition. Artificial intelligence (AI) shows promise in improving early detection, risk

Introduction Sepsis is a life-threatening condition, and fungal pathogens are an increasingly important cause, especially in high-risk groups. During COVID-19, fungal co-infections gained significant attention

Introduction Sepsis is a critical medical emergency caused by an uncontrolled immune response to infection, resulting in organ dysfunction. It continues to be a major

Introduction Antimicrobial resistance (AMR) is a major global health threat. According to the CDC (2019), over 2.8 million antibiotic-resistant infections and 35,000 deaths occur annually

Introduction Antibiotic-resistant bacteria are a growing global threat, causing longer hospital stays, higher costs, and increased mortality. The rise of multidrug-resistant (MDR), extensively drug-resistant (XDR),

Introduction Invasive fungal infections (IFI) are life-threatening in ICU patients, with rising incidence and persistently high mortality. The increase is linked to complex care needs,

Introduction (Article introduction authored by INCA Editorial Team) Bacterial pneumonia remains a global health challenge with high morbidity and mortality, particularly in vulnerable populations. Community-acquired

Introduction Ventilator-associated pneumonia (VAP) is a common and serious infection in ICU patients who undergo invasive mechanical ventilation for more than 48 hours. It is

Introduction Respiratory distress is the leading cause of NICU admissions. Rapid diagnosis and appropriate treatment are vital for improving outcomes. Mechanical ventilation (MV) is a

Introduction The intensive care unit (ICU) is a fast-paced, high-risk environment where human lives depend on rapid, precise decisions. Despite technological advancements, human and system-related

Introduction Candida species are a major cause of hospital-acquired fungal infections, leading to significant illness and death, especially in critically ill or immunocompromised patients. While

Introduction The rise of antimicrobial resistance, especially among Gram-negative bacteria, has led to the development of new β-lactam/β-lactamase inhibitor (BL/BLI) combinations. Recently approved agents—cefepime/enmetazobactam, aztreonam/avibactam,

Introduction This post-hoc analysis of a multinational ICU study assessed and compared the clinical profiles, microbiological findings, and outcomes of immunosuppressed versus non-immunosuppressed patients with

Introduction The concept of “time is spine” underscores the importance of early (within 24 hours) or ultra-early (within 12 hours) surgical decompression following spinal cord

Introduction The American Thoracic Society, CDC, European Respiratory Society, and IDSA have updated TB treatment guidelines based on recent clinical trial data. In settings with

Introduction Recurrent urinary tract infections (UTIs) are defined as 2 infections in 6 months or 3 in 12 months, with at least 2 weeks of

Introduction Nosocomial lower respiratory tract infections (nLRTIs), including HAP and VAP, remain a major healthcare burden due to high mortality and cost. Traditional culture methods

Introduction Multidrug-resistant organisms (MDROs) are bacteria resistant to at least one antibiotic in three or more antimicrobial categories, posing a serious global health threat. Antimicrobial

Introduction Candidemia and invasive candidiasis continue to pose high morbidity and mortality risks, especially in healthcare settings. With rising fluconazole resistance and limitations of current

Introduction (Article introduction authored by INCA Editorial Team) Sepsis is a life-threatening condition that frequently occurs in ICU patients with major trauma due to their

Introduction (Article introduction authored by INCA Editorial Team) Sepsis, a life-threatening condition caused by a dysregulated immune response to infection, remains a major global health

Introduction (Article introduction authored by INCA Editorial Team) Acinetobacter baumannii complex (ABC), particularly its carbapenem-resistant strains (CRAB), presents a significant challenge due to its high

Introduction Intra-abdominal infections (IAIs) are a significant, often life-threatening condition affecting millions of patients annually, with treatment responsibility typically distributed across various healthcare providers, including

Introduction In recent years, invasive fungal infections have emerged as a significant public health threat, particularly among immunocompromised individuals such as those with HIV/AIDS, uncontrolled
Introduction Invasive fungal diseases (IFD) pose significant morbidity and mortality risks, particularly among immunocompromised patients, but they can also affect non-neutropenic, critically ill adults in
